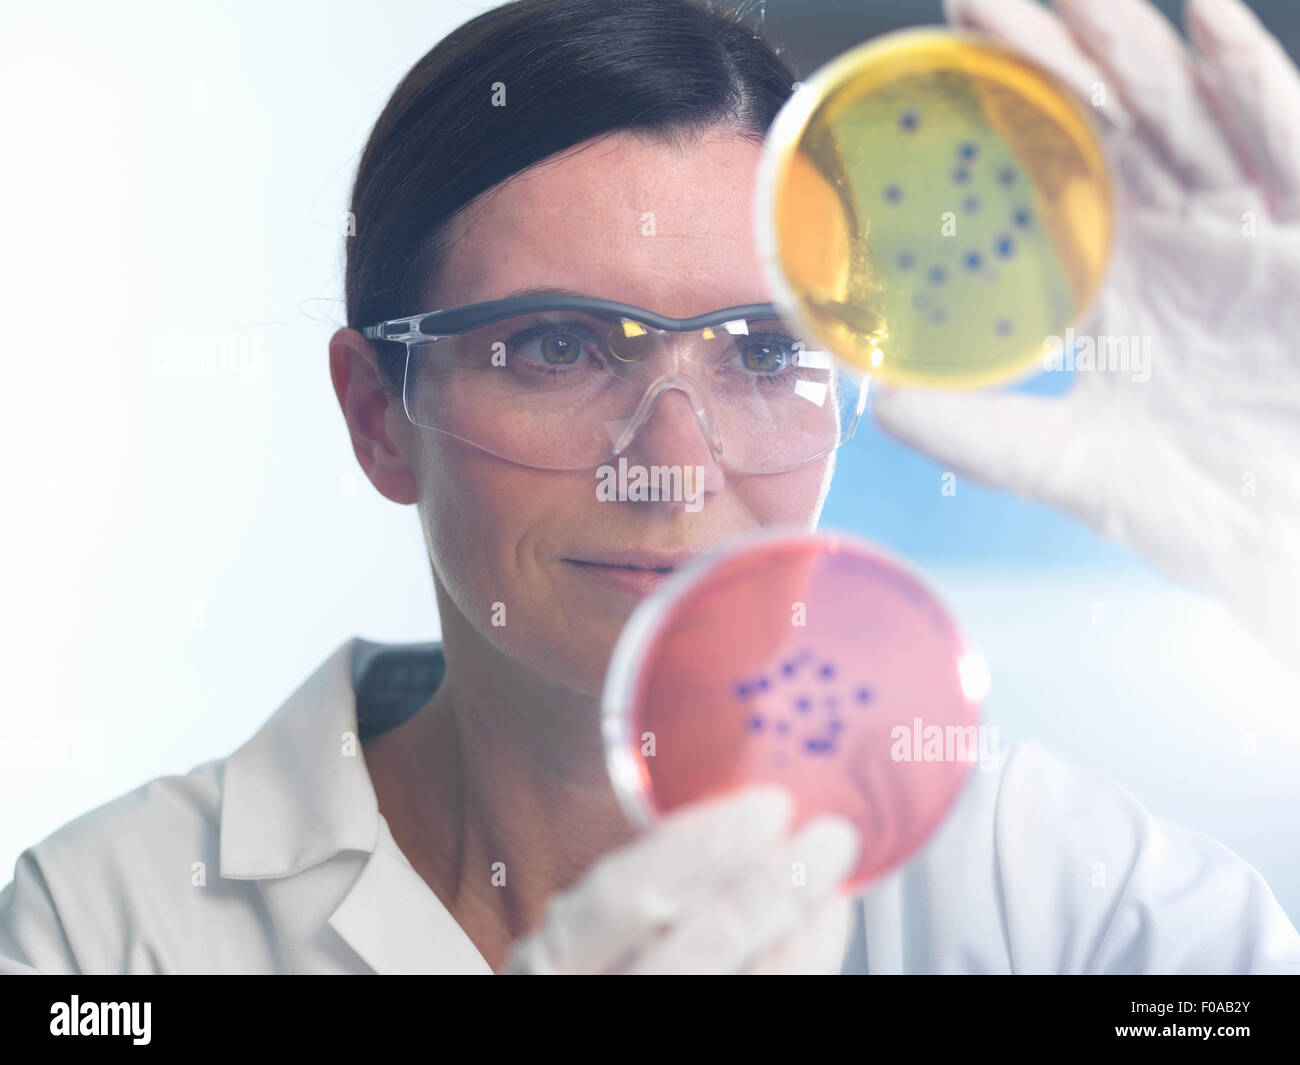
Wissenschaftler untersuchen Satz von Petrischalen im Mikrobiologielabor Stockfoto

Pharmazeutische mikrobiologie Stockfotos & Bilder
(72,118)pharmazeutische mikrobiologie-Stockvideoclips ansehenSchnellfilter:
Pharmazeutische mikrobiologie Stockfotos & Bilder

RF2H67FKF–Ein Reagenzglas mit einer glühenden grünen Flüssigkeit in der Hand eines Wissenschaftlers im Hintergrund des Labors. Synthese einer neuen Substanz im Labor

RF3B178T9–Wissenschaftliche Weiße Mikroskopgeräte im biologischen Chemielabor. Wissenschaftliches Experiment Mikroskop an Labortisch mikrobiologischer Ausrüstung

RF2GE04PM–Bunte Reagenzien in LCMS-Fläschchen mit Kapillare auf UV-Licht in einem Biotechnologielabor für die pharmazeutische Forschung für die Arzneimittelentwicklung

RF2B8CRE8–Wissenschaftlicher Umgang mit einem Lichtmikroskop untersucht eine Laborprobe für die pharmazeutische Biowissenschaftsforschung. Konzept von Wissenschaft, Labor und Studie o

RF2A15TRN–Mikrobiologie, Wissenschaftler anzeigen Kulturen wachsen in Petrischalen unter ein inverses Mikroskop im Labor

RFE5WYG4–Wissenschaftler Pipettieren Probe in eine Petrischale mit kultivierten Bakterien in einem Mikrobiologielabor

RF2X8EH43–Bild mehrerer medizinischer Ikonen gegen gestresste birassische Frau im Krankenhauskorridor

RF2JYWYDP–Laborwissenschaftler, der im Labor mit Mikropipette, Reagenzgläsern und modernem Mikroskop arbeitet. Laborforschung, Mikrobiologie

RF3B178N2–Wissenschaftliche Weiße Mikroskopgeräte im biologischen Chemielabor. Wissenschaftliches Experiment Mikroskop an Labortisch mikrobiologischer Ausrüstung

RF3CJA499–Wissenschaftler, die im Wissenschaftslabor arbeiten. Medizinische Labormitarbeiter, pharmazeutische Medizin Forschungslabor.

RF2B8CREA–Wissenschaftlicher Umgang mit einem Lichtmikroskop untersucht eine Laborprobe für die pharmazeutische Biowissenschaftsforschung. Konzept von Wissenschaft, Labor und Studie o

RF2A15PX7–Mikrobiologie, Wissenschaftler anzeigen Kulturen wachsen in Petrischalen unter ein inverses Mikroskop im Labor

RFE5WYG3–Wissenschaftler Pipettieren Probe in eine Petrischale mit kultivierten Bakterien in einem Mikrobiologielabor

RF2X8EGKP–Bild der medizinischen Schnittstellen über afroamerikanische Wissenschaftlerin, die Proben aus dem Reagenzglas entnimmt

RF2GCRDK2–Petrischale mit Kolonie von Mikroorganismen, die im Labor eines pharmazeutischen Mikrobiologie-Krankenhauses auf dem Tisch stehen. Wissenschaftliche biologische Bakterien flüssige Probe. Medizinisches Bakteriologie-Experiment

RF3B178HC–Wissenschaftliche Weiße Mikroskopgeräte im biologischen Chemielabor. Wissenschaftliches Experiment Mikroskop an Labortisch mikrobiologischer Ausrüstung

RF3CJA49N–Wissenschaftler, die im Wissenschaftslabor arbeiten. Medizinische Labormitarbeiter, pharmazeutische Medizin Forschungslabor.

RF2B8CRDP–Wissenschaftlicher Umgang mit einem Lichtmikroskop untersucht eine Laborprobe für die pharmazeutische Biowissenschaftsforschung. Konzept von Wissenschaft, Labor und Studie o

RF2A166G0–Mikrobiologie, Wissenschaftler anzeigen Kulturen wachsen in Petrischalen unter ein inverses Mikroskop im Labor

RF2BABCB2–Der Pharmaforscher findet eine Lösung für Coronavirus. Konzept der medizinischen Forschung

RFM5TM68–Kochsalzlösung zum Befüllen von Flaschen in der pharmazeutischen Herstellung. Flasche Kochsalzlösung gefüllt wird auf Band.

RF2B7EB1C–Apotheker in medizinischen Handschuhen, die neue Arzneipille in einem pharmazeutischen Labor wiegen. Konzept der pharmazeutischen Industrie

RF2H4R2WD–Ein Wissenschaftler mit einem Reagenzglas in der Hand arbeitet an einer neuen Substanz. Konzept der Pharmazie, Forschung, Biochemie, Mikrobiologie, Medizin, Wissenschaft,

RM2HKDEWH–Kiew, Ukraine - 11. November 2021: Merck, Pfizer auf Papier gedruckt. Covid-Pillen, die von den Pharmariesen Merck und Pfizer entwickelt wurden. Die Pillen könnten sinken

RF2G867EA–Petrischale mit Kolonie von Mikroorganismen, die im Labor eines pharmazeutischen Mikrobiologie-Krankenhauses auf dem Tisch stehen. Wissenschaftliche biologische Bakterien flüssige Probe. Medizinisches Bakteriologie-Experiment

RF3B1792K–Wissenschaftlerin in steriler Kleidung, die am Tisch sitzt und Forschungsuntersuchungen in einem medizinischen Labor mit einem Mikroskop durchführt. Mikrobiologie

RF3CJA3CJ–Wissenschaftler, die im Wissenschaftslabor arbeiten. Medizinische Labormitarbeiter, pharmazeutische Medizin Forschungslabor.

RF2B8CRE2–Wissenschaftlicher Umgang mit einem Lichtmikroskop untersucht eine Laborprobe für die pharmazeutische Biowissenschaftsforschung. Konzept von Wissenschaft, Labor und Studie o

RF2J2T4W0–Junge Wissenschaftlerin mit Mikroskop, während ihre Kollegin im Hintergrund in der Gesundheitsbranche arbeitet

RF2EMJEPX–Medizinisches Forschungslabor: Männlicher Wissenschaftler, Der Unter Micrsokope Schaut Und Proben Analysiert. Advanced Scientific Lab Biotechnologie, Medizin, Mikrobiologie

RF3A18JK0–Ein Spezialist in einem Labor hält eine Flüssigkeit und analysiert sie. Das Konzept: Einsatz von High-Tech-Methoden für genaue Analysen und wissenschaftliche Forschung.

RF2B7EB06–Apotheker in medizinischen Handschuhen, die neue Arzneipille in einem pharmazeutischen Labor wiegen. Konzept der pharmazeutischen Industrie

RF2H4R2WB–Ein Wissenschaftler mit einem Reagenzglas in der Hand arbeitet an einer neuen Substanz. Konzept der Pharmazie, Forschung, Biochemie, Mikrobiologie, Medizin, Wissenschaft,

RF2RHWMHG–Nahaufnahme der Hände einer Frau mit Handschuhen bei der Entnahme einer Probe einer Flüssigkeit aus einem Reagenzglas mit Mikropipette.

RF3B178XJ–Wissenschaftlerin in steriler Kleidung, die am Tisch sitzt und Forschungsuntersuchungen in einem medizinischen Labor mit einem Mikroskop durchführt. Mikrobiologie

RF3CJA3P1–Wissenschaftler, die im Wissenschaftslabor arbeiten. Medizinische Labormitarbeiter, pharmazeutische Medizin Forschungslabor.

RF2B8CRF3–Wissenschaftlicher Umgang mit einem Lichtmikroskop untersucht eine Laborprobe für die pharmazeutische Biowissenschaftsforschung. Konzept von Wissenschaft, Labor und Studie o

RF2J7X8JJ–Laborgeräte, die nach dem Reinigen getrocknet werden. Kolben, Messbecher in Nahaufnahme. Klarglas-Flasche im Forschungslabor für Chemiewissenschaften

RF2K5N3PB–Details zur geringen Schärfentiefe (selektiver Fokus) mit verschiedenen Glasfläschchen, die für alte chemische und medizinische Experimente in einem Museum verwendet werden.